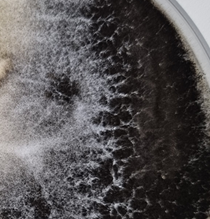
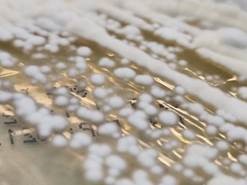
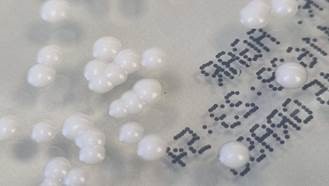

À propos du produit
Détection et isolement d’espèces fongiques pathogènes dans des échantillons cliniques humains et d’autres échantillons.
La gélose Sabouraud Dextrose + Chloramphenicol/Champignon est un milieu sélectif conçu pour la détection qualitative et l'isolement des champignons pathogènes.
Le milieu est recommandé pour la culture d'échantillons contenant une flore bactérienne riche, tels que les expectorations et les prélévements cutanés.
La fonction de la gélose Sabouraud Dextrose + Chloramphénicol/ Champignon est d'aider au diagnostic des patients présentant des symptômes indiquant une infection fongique potentielle.
Les champignons sont classés parmi les agents pathogènes opportunistes. Au cours des dernières décennies, on a observé une augmentation significative de l'incidence des infections fongiques invasives. Cette augmentation s'accompagne d'une morbidité, d'une mortalité excessives et est directement liée à une population croissante de patients à risque, tels que les patients subissant des transfusions sanguines, des transplantations, des interventions chirurgicales majeures, les patients atteints du SIDA, les patients atteints d’un cancer, les patients soumis à des thérapies immunosuppressives et une large population de patients gériatriques et de nouveau-nés prématurés. Parmi les champignons pathogènes pour l'homme, Candida albicans, Cryptococcus neoformans et Aspergillus fumigatus sont le plus souvent isolés dans les infections invasives. En outre, de nombreuses espèces de champignons sont responsables de mycoses de la peau et de ses produits, ainsi que de mycoses des muqueuses du tractus gastro-intestinal ou de l'appareil reproducteur.
Compte tenu des circonstances variables des patients à risque et de la diversité des champignons pathogènes, les mycoses opportunistes posent d'importants défis diagnostiques et thérapeutiques.